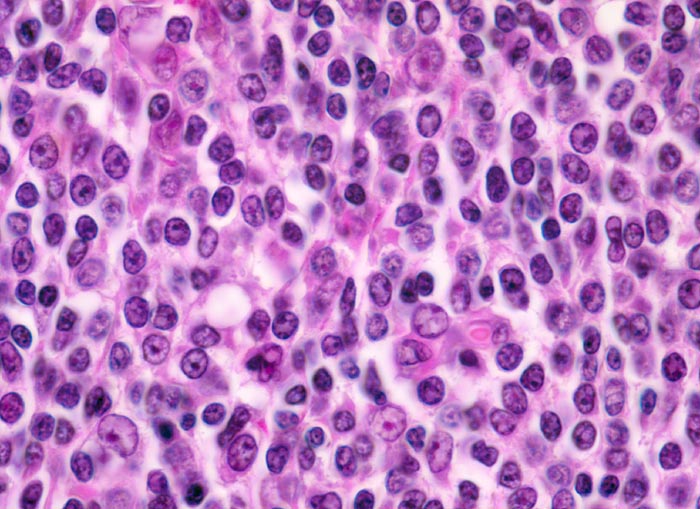

PathoPic – image database / PathoPic ID 3332 - extranodales Marginalzonenlymphom vom MALT-Typ
de
Diagnose
extranodales Marginalzonenlymphom vom MALT-Typ
Diagnose Gruppe
maligner Tumor
Topographie
Magen
Topographie Gruppe
Oesophagus, Magen
Beschreibung
Bilder Typ
Histologie
Vergrösserung
400
Alter
72
Geschlecht
männlich
Datum
Ersteintrag: 12.11.2001